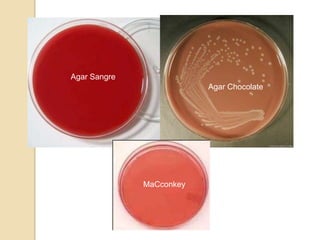
Agar Sangre
                          Agar Chocolate




              MaCconkey

El hemocultivo es un análisis de sangre que permite detectar infecciones en el torrente sanguíneo como la sepsis. Se requiere en casos de fiebre de origen desconocido, endocarditis bacteriana o cuando pacientes con fiebre continúan positivos a pesar del tratamiento antimicrobiano. El procedimiento implica incubar muestras de sangre para permitir el crecimiento de posibles patógenos y luego identificarlos mediante análisis microbiológicos.